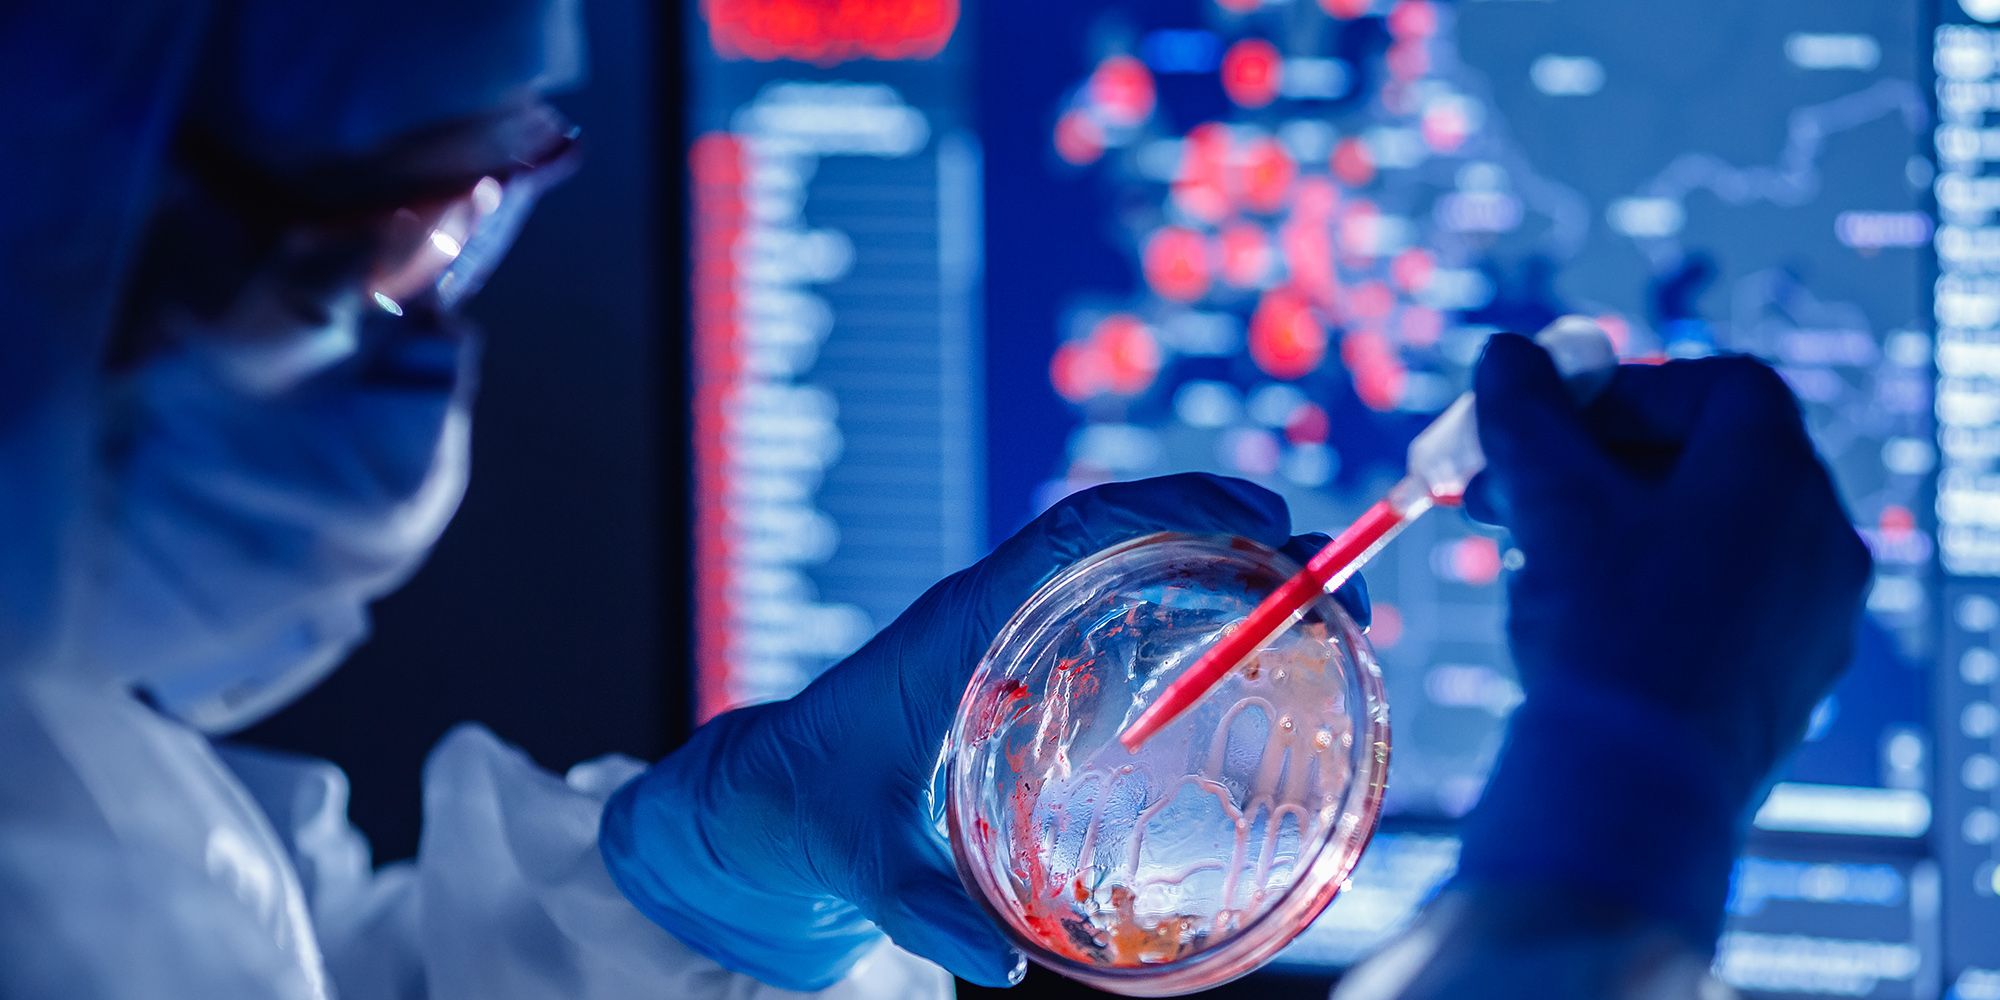
Big UK government funding cut threatens future of cutting-edge African science research

Amir Patel was going to introduce to the world ground-breaking research in biomechanics, where he had applied his inventive mind to reducing the costs of expensive biomechanics equipment by more than 90% for low-cost rehabilitation of people with disabilities and injuries.
Thandazile Moyo — who grew up watching her mother, an unskilled artisanal miner, extract gold from ore using toxic mercury — was going to develop mercury-free extraction technologies for the millions who depend on artisanal mining for income, benefiting both health and the environment.
Dyllon Randall was rethinking the entire field of sanitation by upcycling urine for societal and economic benefit.
As of this week, these and other talented young African researchers who had been selected to receive funding for their salaries and research by a UK-funded scheme recognising future leaders of African science, found their funding cut and their futures uncertain.
The bombshell announcement that one of the major international funding instruments for universities in South Africa — and the rest of Africa — is cutting its budget by half and terminating or reducing most of its grants is just the latest blow to the country’s research enterprise.
It is time for government and business to rethink their support for research.
The Covid-19 pandemic has left almost no sector of society untouched. Among the few silver linings in this very dark cloud is the renaissance of science — scientists the world over have risen to the occasion in extraordinary ways. They have produced highly effective vaccines at warp speed and rapidly pivoted existing research agendas to improve treatment and reduce deaths and severity of the disease and to guide governments on the impact of the pandemic on communities.
South African government-funded research has contributed significantly to this global effort, most notably the network for genomic surveillance (NGS-SA) funded by the Department of Science and Innovation (DSI) and South African Medical Research Council (SAMRC). This is a network of laboratories, scientists and academic institutions that have joined forces to ensure the public health responses to Covid-19 in South Africa have access to the best possible scientific data. It was this network that discovered one of the first SARS-CoV-2 Variants of Concern, which alerted the rest of the world to the possibility that variants with enhanced transmissibility and with immune-evading properties could be evolving.
Such impactful research is, on the whole, expensive, and so is at risk from the global recession induced by the pandemic. The temptation to cut funding for research is great at times of economic hardship, but it is short-sighted. China has long understood that science is critical to its plans for a world-beating economy and is investing heavily in research-intensive universities, with extraordinary results. Some countries are doing the same, both despite and because of the pandemic: Spain, the Netherlands, Sweden and France are among the European nations to have recently announced huge increases in research and innovation spending as part of a stimulus package.
South Africa has taken a different route. As the country’s economy worsens, so research spending has shrunk. As a result, research-intensive South African universities have become increasingly reliant on winning international grants to fund their research. At the University of Cape Town (UCT), the proportion of international grant funding through research-related contracts has increased from 60% in 2015 to more than 75% in 2020. This mobilisation of international funding is contributing extensively to growing Africa’s research footprint; however, it comes at the cost of being able to define our own research agenda.
... focus on the delivery of higher education as well as research and development in South Africa is critical for taking our place in the global knowledge economy and to thrive in the 4IR era.
Some of the most impactful international funding has come from the United Kingdom. South Africa and other countries across the global South have been huge beneficiaries of a strategic decision taken by previous UK governments to funnel components of both its research and aid budgets into collaborative research in low- and middle-income countries (LMIC) through the Official Development Assistance (ODA) programme. The most significant mechanism for distributing this funding is through the £1.5-billion Global Challenges Research Fund (GCRF), with the largest delivery partner being UK Research & Innovation (UKRI).
Although this funding falls within the remit of the ODA, it is very different from traditional aid, and that is the genius of the strategy. Rather than providing handouts to the developing world, it is funding and growing brilliant African science that has an impact in Africa and globally, both now and into the future.
UKRI-funded research at UCT is tackling the most challenging global problems in collaboration with UK universities and universities elsewhere in Africa, including multimillion-rand investment into multinational research groupings that are addressing, among other topics, the overexploitation and pollution of our oceans, the most pressing issues facing Africa’s adolescents, climate change, health challenges on the continent and abroad, home-grown vaccine development, and poverty and inequality. The significant research advances and capacity built by this considerable investment are possibly at risk due to UKRI funding cuts.
Another major beneficiary that is now at risk is funding for research through the African Research Universities Alliance (ARUA), a network of Africa’s most research-led universities, which was founded to increase Africa’s contribution to global knowledge and enhance capacity at Africa’s research institutions. The UKRI has put significant funding into the 13 ARUA Centres of Excellence, which together tackle some of the most intractable problems on the continent and which are playing a valuable role in increasing intra-African collaboration.
This too is facing cuts to about half the levels to date.
Africa needs not only to maintain but also to massively grow its input into the global knowledge project. Solving grand challenges, to deliver on the likes of the UN Sustainable Development Goals (SDGs) and Agenda 2063, requires international collaboration while depending on deep knowledge of local contexts. To ensure this deep and cross-cutting knowledge of local contexts, research activity needs to be embedded across our societies and be not only the preserve of the elite or of “helicopter researchers”.
While international collaboration is critical, some of the best models are for governments in LMICs to co-fund projects with international governments on issues that are pressing for both countries. South Africa already does this very successfully with a host of bilateral arrangements focused on our areas of need; these beg expansion. To do so, the country needs to increase the amount it spends on research and development (R&D) as a percentage of GDP. Despite a faltering economy and competing demands, this is an investment that will reap dividends.
Indeed, focus on the delivery of higher education as well as research and development in South Africa is critical for taking our place in the global knowledge economy and to thrive in the 4IR era.
Can a more coordinated, deliberate and focused national research, development and innovation strategy aligned to the country’s macroeconomic development strategy serve South Africa well? The geo-positioning of South Africa puts us at the centre of the world ocean economy, and our vast land positions logistics, agriculture and possibly manufacturing as potentially good industries with a competitive edge — areas that will be key drivers of the development of our economy.
With R&D as a key driver of this macro-economic strategy, it will ensure that the country becomes a leader in our priority areas, achieving an enhanced trickle-down effect to local economies, with greater spin-offs for the country and the continent. This will have to be supported by a deliberate, prioritised and transformative budget.
Just as importantly, private enterprise and South African philanthropists benefit by investing more in research and innovation. Not only is this a wise investment, but it gives them a voice in the research agenda that improves the country’s future. Collectively, South African alumni can add to this influence by routinely investing in and leaving bequests to their alma maters, choosing research portfolios that resonate with their concerns and values, or simply contributing to an endowment and trusting the institutions to prioritise.
At the same time and taking equal responsibility, South African researchers can increase their collaborations with local government, local industry and local NGOs, not only as a source of funding but to increase uptake and impact of research on local problems.
The onus is on all of us — those providing the funding and those receiving it — to be highly strategic in how we spend it. For instance, the SDGs cannot be tackled one by one: combinations of interventions are most effective. This is precisely the goal of the GCRF-funded Accelerating Achievement for Africa’s Adolescents project, led by the University of Oxford with UCT playing a significant role. This hub turned out to be brilliantly placed to pivot towards the pandemic, identifying key initiatives responding to pressing needs exacerbated by the pandemic in South Africa. And yet the work of this team is now at risk.
Research is massively transformative, delivering both targeted knowledge and the next generation of researchers and thought leaders for our nation and our continent, but it needs healthy funding and strategic investment. Otherwise, we stand to lose those with the talents and skills to make a difference on the ground, like Thandazile Moyo, and the world stands to lose the existing and potential brilliance of African science. DM
Prof Sue Harrison is Deputy Vice-Chancellor for Research and Internationalisation and Dr Linda Mtwisha is Executive Director, Research, at the University of Cape Town.

Living substances in which biopharmaceuticals are produced include micro-organisms such as bacteria and yeast and living cell lines including mammalian, insect, plant, and even human cell lines. (Photo: Adobe Stock)
Living substances in which biopharmaceuticals are produced include micro-organisms such as bacteria and yeast and living cell lines including mammalian, insect, plant, and even human cell lines. (Photo: Adobe Stock)